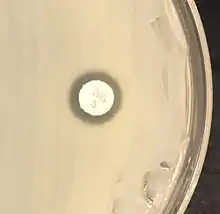
"S. saprophyticus" on Mueller–Hinton agar exhibiting resistance to novobiocin characteristic for species identification

Staphylococcus saprophyticus
Staphylococcus saprophyticus is a Gram-positive coccus belonging to the genus Staphylococcus.[1] S. saprophyticus is a common cause of community-acquired urinary tract infections.[2][3]
| Staphylococcus saprophyticus | |
|---|---|
![]() | |
| S. saprophyticus on Mueller–Hinton agar exhibiting resistance to novobiocin characteristic for species identification | |
| Scientific classification | |
| Domain: | Bacteria |
| Phylum: | Bacillota |
| Class: | Bacilli |
| Order: | Bacillales |
| Family: | Staphylococcaceae |
| Genus: | Staphylococcus |
| Species: | S. saprophyticus |
| Binomial name | |
| Staphylococcus saprophyticus (Fairbrother 1940) Shaw et al. 1951 | |
History
Staphylococcus saprophyticus was not recognized as a cause of urinary tract infections until the early 1970s, more than 10 years after its original demonstration in urine specimens. Prior to this, the presence of coagulase-negative staphylococci (CoNS) in urine specimens was dismissed as contamination.
Epidemiology and pathogenesis
In humans, S. saprophyticus is found in the normal flora of the female genital tract[3] and perineum.[4] It has been isolated from other sources, too, including meat and cheese products, vegetables, the environment, and human and animal gastrointestinal tracts.[4] S. saprophyticus causes 10–20% of urinary tract infections (UTIs). In females 17–27 years old, it is the second-most common cause of community-acquired UTIs, after Escherichia coli.[5] Sexual activity increases the risk of S. saprophyticus UTIs because bacteria are displaced from the normal flora of the vagina and perineum into the urethra.[3] Most cases occur within 24 hours of sex,[3] earning this infection the nickname "honeymoon cystitis".[6] S. saprophyticus has the capacity to selectively adhere to human urothelium. The adhesin for S. saprophyticus is a lactosamine structure. S. saprophyticus produces no exotoxins.[3]
Clinical features
Patients with urinary tract infections caused by S. saprophyticus usually present with symptomatic cystitis. Symptoms include a burning sensation when passing urine, the urge to urinate more often than usual, a 'dripping effect' after urination, weak bladder, a bloated feeling with sharp razor pains in the lower abdomen around the bladder and ovary areas, and razor-like pains during sexual intercourse. Flank pain may occur due to infection of the upper urinary tract, such as pyelonephritis. Signs and symptoms of renal involvement are also often registered.[7]
Laboratory diagnosis
The urine sediment of a patient with a S. saprophyticus urinary tract infection has a characteristic appearance under the microscope manifesting leukocytes, erythrocytes, and clumping due to cocci adhering to cellular elements. Chemical screening methods for bacteriuria, such as, urine nitrate and glucose do not always detect S. saprophyticus infection. This is because unlike Gram-negative Enterobacteriaceae urinary tract infections, S. saprophyticus does not reduce nitrate and has a longer generation time, thus does not consume glucose as rapidly. Even when such an infection occurs above the neck of the bladder, low numbers of colony-forming units (less than 105 cfu/ml) are often present.[8]
Staphylococcus saprophyticus is identified as belonging to the genus Staphylococcus using the Gram stain and catalase test. It is identitified as a species of coagulase-negative staphylococci (CoNS) using the coagulase test. Lastly, S. saprophyticus is differentiated from S. epidermidis, another species of pathogenic CoNS, by testing for susceptibility to the antibiotic novobiocin. S. saprophyticus is novobiocin-resistant, whereas S. epidermidis is novobiocin-sensitive.[3]
Treatment
Staphylococcus saprophyticus urinary tract infections are usually treated with trimethoprim-sulfamethoxazole or with a quinolone such as to be alone norfloxacin.[3] It has also been shown to be susceptible to ampicillin & ceftriaxone.[9]
The many home remedies or natural treatments for urinary tract infections are not clinically proven, such as cranberry juice, alkalinization, and many types of common herbs and spices. Some show promise, such as to affect the formation of biofilms on surfaces or medical equipment, and in other in vitro situations.[10][11][12][13][14][15]
Different subspecies
Two subspecies of S. saprophyticus exist: S. s. bovis and S. s. saprophyticus, the latter has colony diameter of > 5mm, and more commonly found in human UTIs. S. s. saprophyticus is nitrate-reductase negative and pyrrolidonyl-arylamidase negative, while S. saprophyticus bovis has colony diameter of < 5mm, nitrate-reductase positive and pyrolidonyl-arylamidase positive.[16]
References
- Schleifer, K. H.; Kloos, W. E. (1975). "Isolation and characterization of Staphylococci from human skin I. Amended descriptions of Staphylococcus epidermidis and Staphylococcus saprophyticus and descriptions of three new species: Staphylococcus cohnii, Staphylococcus haemolyticus, and Staphylococcus xylosus". International Journal of Systematic Bacteriology. 25 (1): 50–61. doi:10.1099/00207713-25-1-50. ISSN 0020-7713.
- Kuroda, M.; Yamashita, A.; Hirakawa, H.; Kumano, M.; et al. (September 2005). "Whole genome sequence of Staphylococcus saprophyticus reveals the pathogenesis of uncomplicated urinary tract infection". Proc. Natl. Acad. Sci. U.S.A. 102 (37): 13272–7. Bibcode:2005PNAS..10213272K. doi:10.1073/pnas.0502950102. PMC 1201578. PMID 16135568.
- Levinson, W. (2010). Review of Medical Microbiology and Immunology (11th ed.). pp. 94–9.
- Widerström, M.; Wiström, J.; Sjöstedt, A.; Monsen, T. (January 2012). "Coagulase-negative Staphylococci: Update on the molecular epidemiology and clinical presentation, with a focus on Staphylococcus epidermidis and Staphylococcus saprophyticus". European Journal of Clinical Microbiology & Infectious Diseases. 31 (1): 7–20. doi:10.1007/s10096-011-1270-6. PMID 21533877. S2CID 7162887.
- Rupp, M. E.; Soper, D. E.; Archer, G. L. (November 1992). "Colonization of the female genital tract with Staphylococcus saprophyticus". Journal of Clinical Microbiology. 30 (11): 2975–9. doi:10.1128/JCM.30.11.2975-2979.1992. PMC 270562. PMID 1452668.
- "Understanding Bladder Infections -- the Basics". WebMD. Retrieved 4 December 2013.
- Jordan, P. A.; Iravani, A.; Richard, G. A.; Baer, H. (October 1980). "Urinary tract infection caused by Staphylococcus saprophyticus". The Journal of Infectious Diseases. 142 (4): 510–5. doi:10.1093/infdis/142.4.510. PMID 7192302.
- Hovelius, B.; Mårdh, P. A. (May 1984). "Staphylococcus saprophyticus as a common cause of urinary tract infections". Reviews of Infectious Diseases. 6 (3): 328–37. doi:10.1093/clinids/6.3.328. PMID 6377440.
- Marrie, T. J.; Kwan, C. (1982). "Antimicrobial susceptibility of Staphylococcus saprophyticus and urethral staphylococci". Antimicrob Agents Chemother. 22 (3): 395–7. doi:10.1128/aac.22.3.395. PMC 183755. PMID 6982679.
- Nostro, A.; Cellini, L.; Di Giulio, M.; D'Arrigo, M.; et al. (September 2012). "Effect of alkaline pH on staphylococcal biofilm formation". APMIS. 120 (9): 733–42. doi:10.1111/j.1600-0463.2012.02900.x. PMID 22882263. S2CID 23267457.
- LaPlante, K. L.; Sarkisian, S. A.; Woodmansee, S.; Rowley, D. C.; et al. (September 2012). "Effects of cranberry extracts on growth and biofilm production of Escherichia coli and Staphylococcus species". Phytotherapy Research. 26 (9): 1371–4. doi:10.1002/ptr.4592. PMID 22294419. S2CID 5881493.
- "Nlss.org.in" (PDF). nlss.org.in. Retrieved 27 February 2019.
- Lee, W. H.; Loo, C. Y.; Bebawy, M.; Luk, F.; et al. (July 2013). "Curcumin and its derivatives: Their application in neuropharmacology and neuroscience in the 21st century". Current Neuropharmacology. 11 (4): 338–78. doi:10.2174/1570159X11311040002. PMC 3744901. PMID 24381528.
- Roy, H.; Dare, K.; Ibba, M. (February 2009). "Adaptation of the bacterial membrane to changing environments using aminoacylated phospholipids". Molecular Microbiology. 71 (3): 547–50. doi:10.1111/j.1365-2958.2008.06563.x. PMC 2774118. PMID 19054327.
- "Peterborough Regional Science Fair". peterboroughsciencefair.org. Retrieved 27 February 2019.
- Hájek, V.; Meugnier, H.; Bes, M.; Brun, Y.; et al. (July 1996). "Staphylococcus saprophyticus subsp. bovis subsp. nov., isolated from bovine nostrils" (PDF). International Journal of Systematic Bacteriology. 46 (3): 792–6. doi:10.1099/00207713-46-3-792. PMID 8782691.